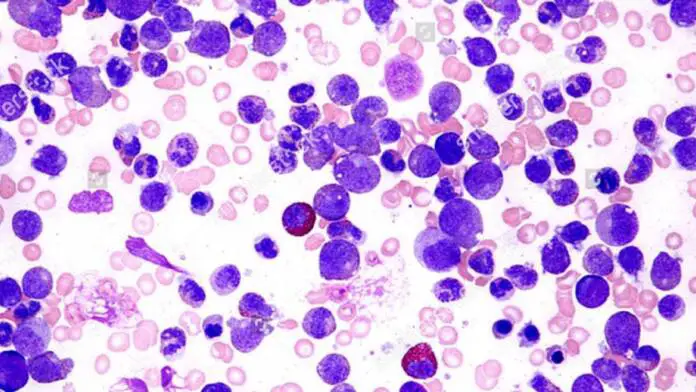
LLC

En el marco del 6º Congreso del Grupo Latinoamericano de Leucemia Linfocítica Crónica (LAG-CLL Meeting 2026), que se desarrolla este jueves y viernes en la provincia de Mendoza, investigadores y hematólogos internacionales presentan avances que marcan un antes y un después en el abordaje del cáncer de sangre más común en adultos.
La leucemia linfocítica crónica (LLC) se origina en los linfocitos y se caracteriza por una evolución lenta. Sin embargo, en la última década, la aparición de terapias innovadoras ha transformado el pronóstico de los pacientes, ofreciendo un escenario mucho más favorable que el de años anteriores.
El fin de la era de la quimioterapia
Uno de los ejes centrales del congreso es la consolidación de las terapias dirigidas e inmunoterapias como el nuevo estándar de tratamiento, desplazando a la quimioterapia tradicional.
La Dra. M. Silvana Cugliari, jefa de hematología del Instituto Roffo-UBA, destacó que la tendencia actual se inclina hacia el uso de monoterapias o la combinación de hasta tres fármacos con mecanismos de acción complementarios. Estos esquemas permiten alcanzar altas tasas de eficacia con una precisión mucho mayor.
Por su parte, el Dr. Miguel A. Pavlovsky, director Médico Científico de FUNDALEU, subrayó que la evidencia sobre los beneficios de estas estrategias es «contundente» y cambia radicalmente la forma de abordar la enfermedad mediante tratamientos que actúan de manera sinérgica.
Hacia una medicina personalizada y de tiempo acotado
A diferencia de los esquemas históricos, las nuevas combinaciones terapéuticas presentan ventajas significativas para la calidad de vida de quienes transitan la enfermedad:
Tratamientos finitos: Algunos esquemas se administran por períodos determinados (de uno o dos años) y luego se suspenden, manteniendo el control de la leucemia bajo seguimiento médico.
Mejor tolerancia: Al evitar la quimioterapia, los pacientes experimentan un menor impacto físico, lo que les permite continuar con su vida habitual.
Precisión: El desafío actual de la ciencia es identificar qué perfil de paciente se beneficia más de cada opción para avanzar hacia una medicina cada vez más personalizada.
La importancia de la investigación traslacional
La Dra. Romina Gamberale, investigadora del CONICET, enfatizó que el trabajo conjunto entre el laboratorio y la clínica es vital. El conocimiento sobre cómo interactúan las células malignas con su entorno permite descubrir nuevos «blancos terapéuticos» y desarrollar opciones más efectivas.
Este congreso en Mendoza se posiciona como el evento científico más importante de la región sobre LLC, funcionando como un espacio esencial para traducir los descubrimientos científicos en beneficios directos y tangibles para los pacientes latinoamericanos.
Fuente: Cadena 3.